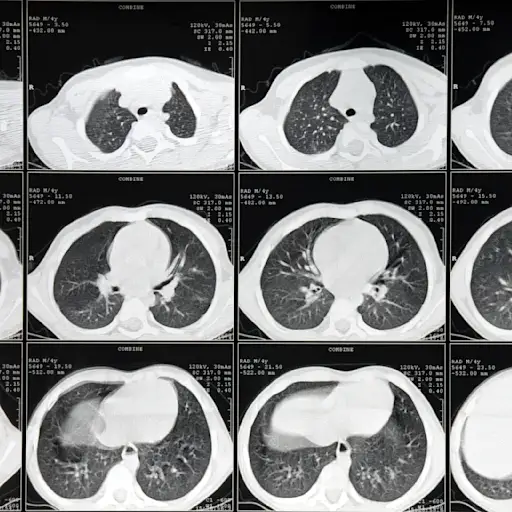

10个关于肺癌的误区被揭穿

肺部进步癌症的研究和治疗从未持有过现在的承诺,而且诊断后的更多人比以往任何时候都在诊断。那是好消息!根据美国肺协会的说法,即使是这种疾病,普遍性和危险的神话仍然仍然比例起到541,000名美国人。关于谁得到它以及如何检测到和治疗的谁可以过性,甚至防止已经显示出显着提高生存率的早期筛查。这里有10个肺癌神话,你根本无法承受不得不相信。

误解1:大学毕业后我就没抽过烟。我肯定我很好。
好吗?当然。没有风险?不。您当前发育肺癌的当今风险与您在当天熏制的程度有关;现在和你的最后一个粉扑之间的年数;此外,雅各布沙滩,M.D.Andants在波士顿Dana-Farber癌症研究所的胸泡桑德斯,M.D.仍然,“戒烟是你可以为肺部健康做的最好的东西,”他补充道。最近的研究揭示了吸烟者(每天23个或更多CIGS)在戒烟五年内将其风险降低了39%。

神话2:肺癌是吸烟者的健康问题 - 不是吸烟者,就像我一样。
尽管到目前为止,吸烟仍然是导致肺癌的最大风险因素——根据美国疾病控制与预防中心(Centers for Disease Control and prevention)的数据,至少80%的肺癌死亡与吸烟有关——但吸烟并不是唯一的原因。美国癌症协会报告称,每年死于肺癌的人中有五分之一从不吸烟。相反,从不吸烟的人可能暴露在氡、二手烟、石棉或其他有毒化学物质中。桑兹博士说:“有很多人根本没有接触过这种疾病。”

神话#3:肺癌手术实际上会导致疾病传播。
“一个非常常见的误解,”Tawee Tanvetyanon,M.D.,坦帕,普拉斯州H. Lee Moffitt癌症中心研究所和肺癌专家Tawee Tanvetyanon。当初始手术期间不能删除100%的癌症时,他怀疑发生混乱。“此外,在手术时可能存在更多的癌症,而不是最初怀疑。”他维持,这是一个肯定需要破坏的神话。“我总是承认对患者的恐惧,但也让他们知道如果他们没有手术,那么事情会更快地变得更糟。”

误解4:长时间剧烈的咳嗽肯定是癌症的线索。
肺癌是一种隐蔽性疾病,通常没有明显的症状,尤其是仅局限于肺部时。此外,“肺癌最常见的症状,如咳嗽、呼吸急促、胸痛和体重减轻,也是肺气肿和肺炎等其他问题的常见指标,”纽约布法罗罗斯威尔公园综合癌症中心的主治胸外科医生和肿瘤学副教授Elisabeth Dexter医学博士说。“从本质上说,这意味着没有泄露秘密的迹象。”她建议,如果上述任何一种症状持续存在,或者你受到新的、无法解释的呼吸短促或持续咳嗽的影响,你应该尽快去看医生。

误解5:肺癌基本上是老年人的疾病。
这对此有一些真相“如果你考虑65并超过65人,”德克斯特博士说。实际上,70是肺癌诊断的平均年龄。然而,这种疾病,特别是在非吸烟者和女性中,生活中早些时候就会发生。2020年的研究国际癌症杂志研究发现,年龄在30岁至49岁之间的女性被诊断出肺癌的比例高于男性,而性别之间吸烟习惯的差异并不能完全解释这种模式。底线:如果你有症状(参见误区4),无论你的年龄如何,请咨询你的医疗保健提供者。
误解6:肺癌没有标准的筛查方法。
“许多初级保健医生不完全了解肺癌筛查的好处,所以他们不告诉病人——这是不好的,考虑到70%的筛查发现的肺癌处于早期阶段,因此是可以治愈的,”桑兹博士说。目前,只有2%符合每年低剂量CT扫描肺癌筛查标准的人接受了筛查。55岁至77岁才有资格;健康的相对健康的;每天(至少)抽20支烟,30年;或每天抽两包烟,15年;现在你吸烟;或者是在过去15年内戒掉的。

误解7:化疗、放疗和手术是我唯一的治疗选择。
今天,有针对性的治疗的众所周知的是大约四分之一的腺癌,最常见的非小细胞肺癌形式提供新的希望。这种方法实际上蜂拥而至并杀死携带某些DNA突变的癌细胞而不损坏健康细胞,与化疗或辐射不同。“在非小细胞肺癌治疗中革命性,”沙博士说。他补充说,任何被诊断出患有腺癌的NSCLC都需要进行测试,以了解有针对性的治疗是否可以为他们工作。“这被认为是护理标准,但令人惊讶的是,不是每个人都在完成它 - 所以问。”

神话#8:我自己的免疫系统不能被杀死杀死癌细胞。
同时,免疫疗法是一种生物学方法,用于使用药物来帮助激活免疫系统识别 - 然后灭绝 - 癌细胞。“现在,免疫疗法常规用于所有患有第3阶段和4阶段肺癌的患者,”Tanvetyanon博士说。“转化为肺癌患者的约60%至70%。”肺癌的免疫疗法只有广泛的可用大约五年,但它已经产生了很大的影响。“免疫疗法有助于将大约15%〜20%的阶段癌症患者转化为长期幸存者,”他说。

迷思9:吸电子烟能降低患病风险。
事实上,电子烟(又称电子烟笔或喷雾器)还没有出现很长时间,所以还不确定。我们所知道的是,它们“充满了能损害肺部的重要化学物质,”桑兹博士说。根据美国癌症协会的说法,这些有害化学物质是致癌的,即使它们的含量远远低于普通香烟。尽管如此,截至2020年1月,已有近3000人因电子烟相关的肺部损伤而住院治疗。电子烟是否能提高戒烟成功率仍然不确定,这可能就是为什么FDA尚未批准任何电子烟产品作为戒烟工具的原因。

神话#10:在肺癌诊断后戒烟是毫无意义的。
立即停止此虚假概念。“在肺癌诊断时戒烟的患者对其癌症治疗具有更好的反应,和德克斯特博士说,它们在肺癌外科博士博士说,他们经历了更少的并发症和更好的存活率。“加上任何癌症诊断后,踢习惯有助于降低继发性癌症的风险,即使在2019年期间的2019年报告,据了一个人的生活质量增加翻译肺癌研究.我们知道戒烟并不容易,如果你需要支持,就去美国肺协会学习如何做。